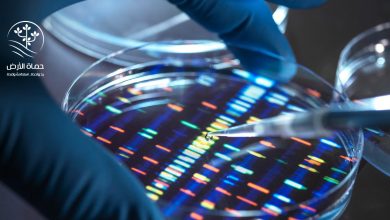
الجينوم

الطب الجيني
-
أخبار الاستدامة

إنجاز علمي.. الجينوم البشري في أول تحليل كامل بأياد مصرية
إنجاز علمي.. الجينوم البشري في أول تحليل كامل بأياد مصرية أصبحت العلاقة بين العلم والتنمية أكثر تداخلًا في السنوات الأخيرة،…
أكمل القراءة »
إنجاز علمي.. الجينوم البشري في أول تحليل كامل بأياد مصرية أصبحت العلاقة بين العلم والتنمية أكثر تداخلًا في السنوات الأخيرة،…
أكمل القراءة »